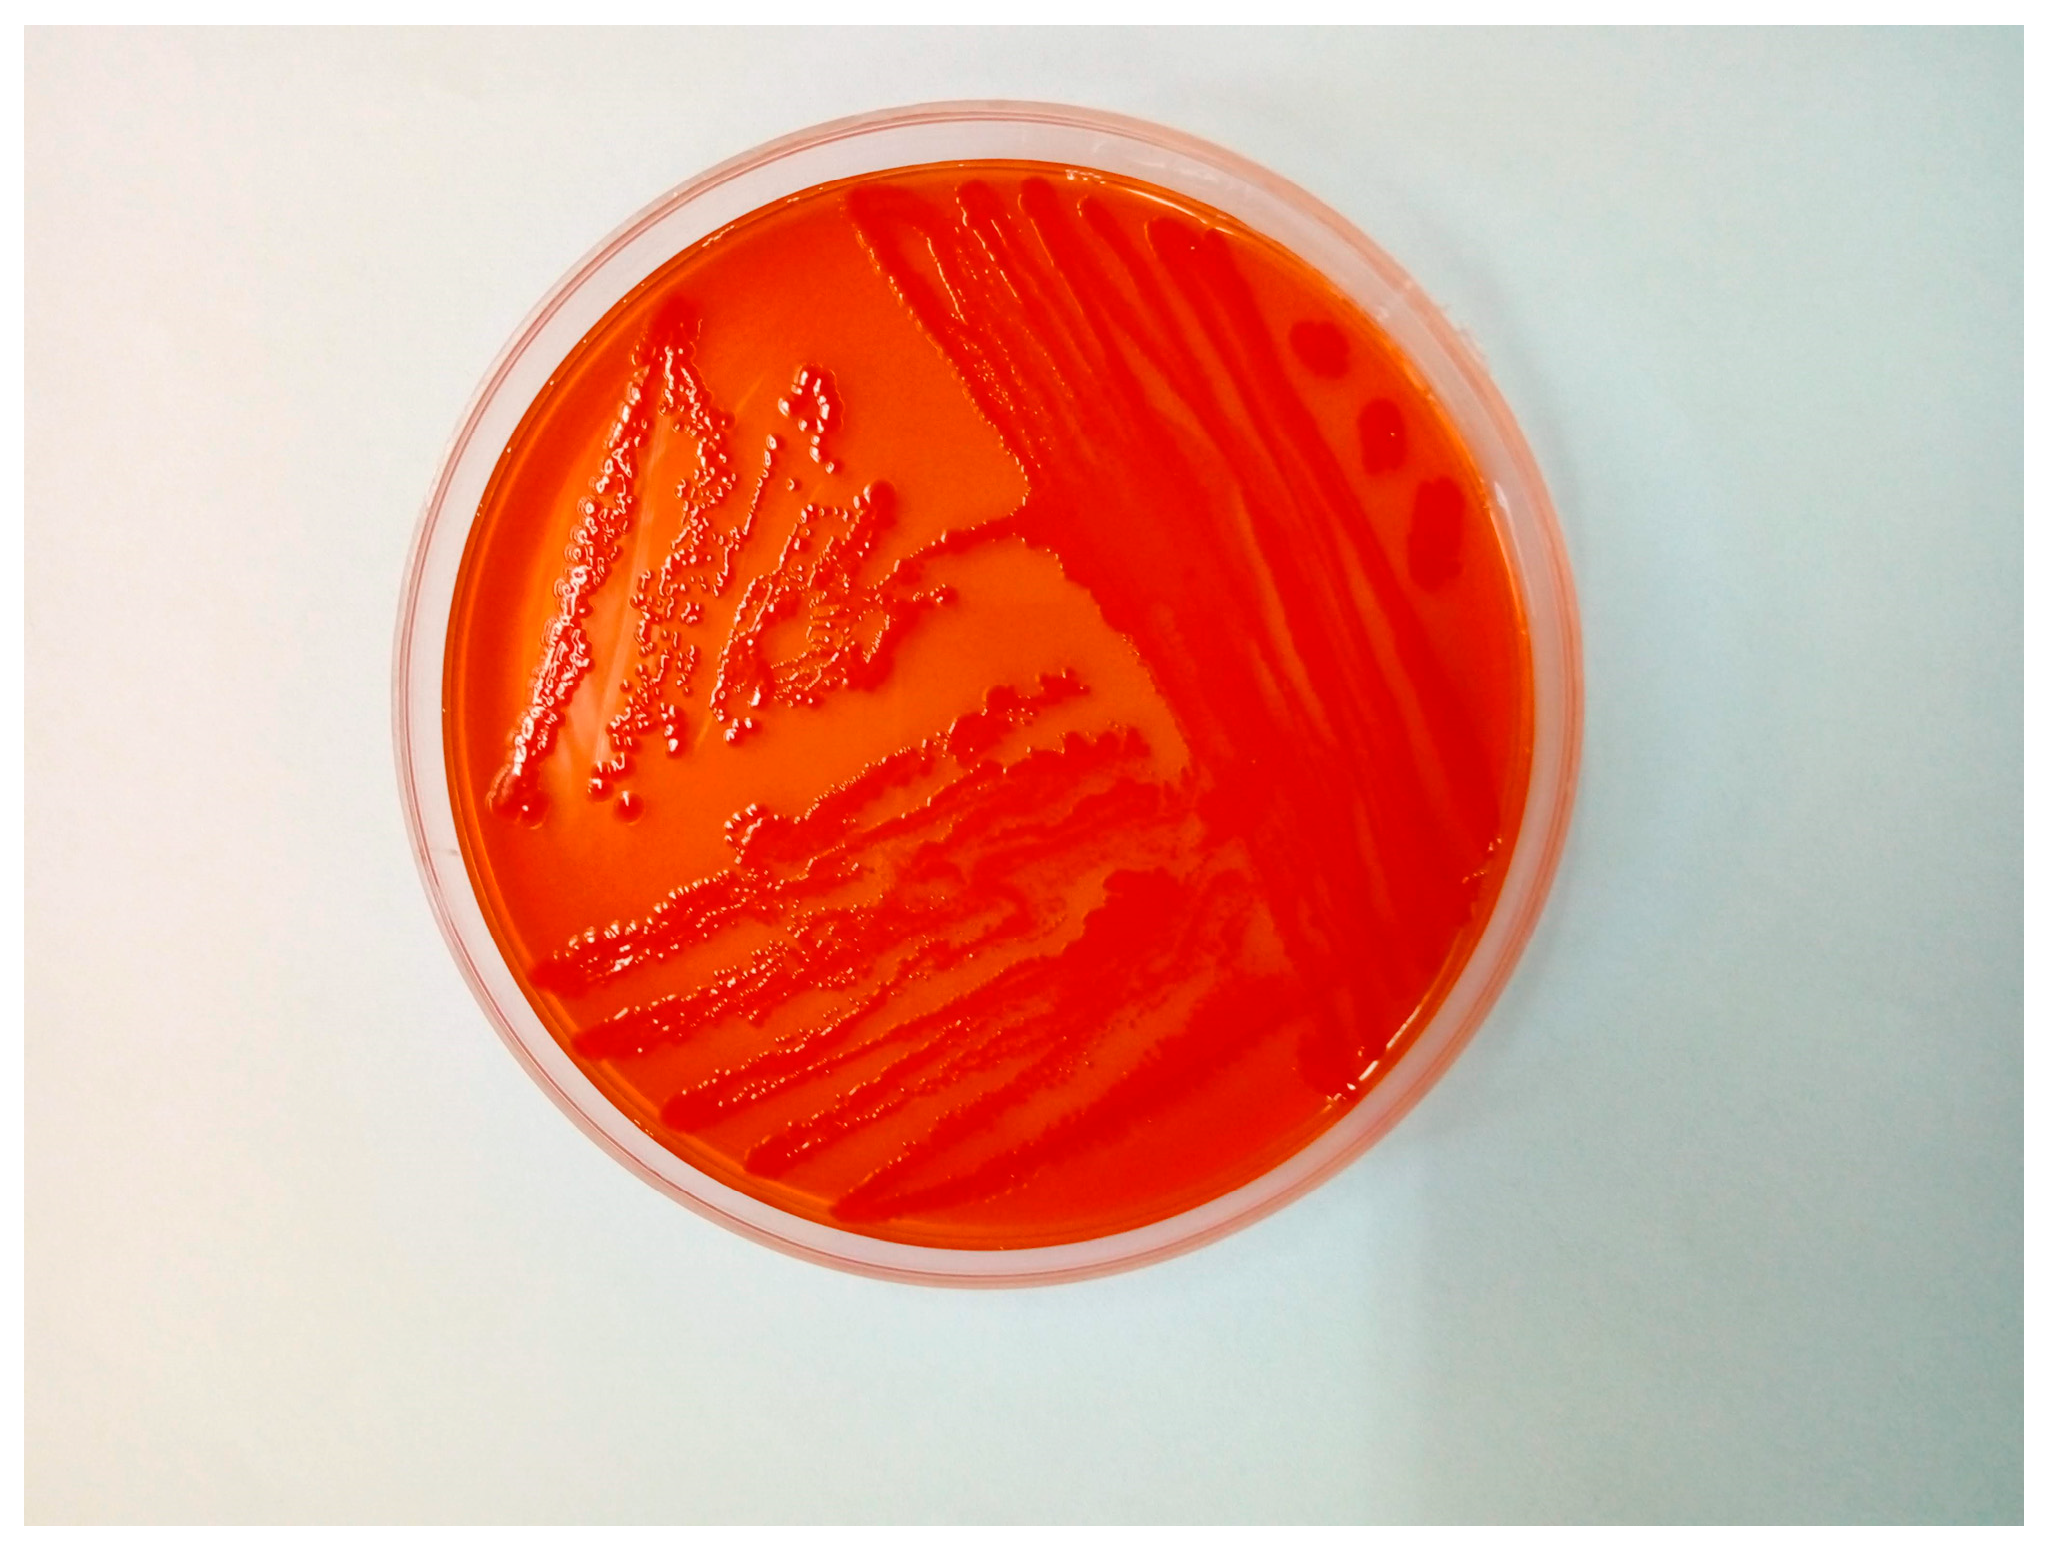

Multidrug-Resistant Escherichia coli Associated with Respiratory and Systemic Infection in a Domestic Rabbit in Romania: First Confirmed Case
Abstract
1. Introduction
2. Case Study
3. Discussion
4. Conclusions
Author Contributions
Funding
Institutional Review Board Statement
Informed Consent Statement
Data Availability Statement
Acknowledgments
Conflicts of Interest
References
- Javed, M.U.; Hayat, M.T.; Mukhtar, H.; Imre, K. CRISPR-Cas9 System: A Prospective Pathway toward Combatting Antibiotic Resistance. Antibiotics 2023, 12, 1075. [Google Scholar] [CrossRef]
- Bharadwaj, A.; Rastogi, A.; Pandey, S.; Gupta, S.; Sohal, J. Multidrug-Resistant Bacteria: Their Mechanism of Action and Prophylaxis. Biomed. Res. Int. 2022, 2022, 5419874. [Google Scholar] [CrossRef] [PubMed]
- Nikaido, H. Multidrug resistance in bacteria. Annu. Rev. Biochem. 2009, 78, 119–146. [Google Scholar] [CrossRef] [PubMed]
- Magiorakos, A.; Srinivasan, A.; Carey, R.; Carmeli, Y.; Falagas, M.; Giske, C.; Harbarth, S.; Hindler, J.; Kahlmeter, G.; Olsson-Liljequist, B.; et al. Multidrug-resistant, extensively drug-resistant and pandrug-resistant bacteria: An international expert proposal for interim standard definitions for acquired resistance. Clin. Microbiol. Infect. 2012, 18, 268–281. [Google Scholar] [CrossRef] [PubMed]
- Macesic, N.; Uhlemann, A.; Peleg, A. Multidrug-resistant Gram-negative bacterial infections. Lancet 2025, 405, 257–272. [Google Scholar] [CrossRef]
- Silva, A.; Silva, V.; Tavares, T.; López, M.; Rojo-Bezares, B.; Pereira, J.; Falco, V.; Valentão, P.; Igrejas, G.; Sáenz, Y.; et al. Rabbits as a Reservoir of Multidrug-Resistant Escherichia coli: Clonal Lineages and Public Health Impact. Antibiotics 2024, 13, 376. [Google Scholar] [CrossRef]
- Sun, C.; Wang, Z.; Li, Y.; Huang, J. Antibiotic resistance spectrums of Escherichia coli and Enterococcus spp. strains against commonly used antimicrobials from commercial meat-rabbit farms in Chengdu City, Southwest China. Front. Vet. Sci. 2024, 11, 1369655. [Google Scholar] [CrossRef]
- Chai, M.; Sukiman, M.; Jasmy, N.; Zulkifly, N.; Yusof, N.; Mohamad, N.; Ariffin, S.; Ghazali, M. Molecular Detection and Antibiogram of ESBL-Producing and Carbapenem-Resistant Escherichia coli from Rabbit, Swine, and Poultry in Malaysia. Trop. Anim. Sci. J. 2022, 45, 16–24. [Google Scholar] [CrossRef]
- Silva, N.; Igrejas, G.; Figueiredo, N.; Gonçalves, A.; Radhouani, H.; Rodrigues, J.; Poeta, P. Molecular characterization of antimicrobial resistance in enterococci and Escherichia coli isolates from European wild rabbit (Oryctolagus cuniculus). Sci. Total Environ. 2010, 408, 4871–4876. [Google Scholar] [CrossRef]
- Jones, R.; Seo, H.; Zhang, W.; Sack, D. A multi-epitope fusion antigen candidate vaccine for Enterotoxigenic Escherichia coli is protective against strain B7A colonization in a rabbit model. PLoS Negl. Trop. Dis. 2022, 16, e0010177. [Google Scholar] [CrossRef]
- Tischenko, A. Histopathological Changes in Experimental Escherichia Infection Caused by Escherichia coli Exotoxins. Bull. KSAU 2024, 4, 128–135. [Google Scholar] [CrossRef]
- Swennes, A.; Buckley, E.; Parry, N.; Madden, C.; García, A.; Morgan, P.; Astrofsky, K.; Fox, J. Enzootic Enteropathogenic Escherichia coli Infection in Laboratory Rabbits. J. Clin. Microbiol. 2012, 50, 2353–2358. [Google Scholar] [CrossRef]
- García, A.; Fox, J. The Rabbit as a New Reservoir Host of Enterohemorrhagic Escherichia coli. Emerg. Infect. Dis. 2003, 9, 1592–1597. [Google Scholar] [CrossRef]
- Kang, G.; Pulimood, A.; Mathan, M.; Mathan, V. Enteroaggregative Escherichia coli Infection in a Rabbit Model. Pathology 2001, 33, 341–346. [Google Scholar] [CrossRef]
- Eladl, A.; Farag, V.; El-Shafei, R.; Elkenany, R.; Elsayed, M.; Mona, M.; Ali, H.; Saif, M. Effect of colibacillosis on the immune response to a rabbit viral haemorrhagic disease vaccine. Vet. Microbiol. 2019, 238, 108429. [Google Scholar] [CrossRef]
- Saravia, M.; Segovia, C.; Valderrama, K.; Santander, J. Colibacillosis in a New Zealand white rabbit (Oryctolagus cuniculus). J. Infect. Dev. Ctries. 2017, 11, 203–206. [Google Scholar] [CrossRef] [PubMed][Green Version]
- Skrypka, M.; Tul, O.; Kyrychko, B. Pathomorphological Changes in Organs of Rabbits with Experimental Colibacillosis. Bull. Univ. Agric. Sci. Vet. Med. Cluj-Napoca Hortic. 2020, 77, 35. [Google Scholar] [CrossRef]
- Camer, G.; Roh, Y.; Cho, A.; Kim, J.; Umanets, A.; Kim, B.; Lim, S.; Lee, H.; Lim, C. A case of nonserotypable Escherichia coli infection in a Korean rabbit farm. Korean J. Vet. Serv. 2012, 35, 69–71. [Google Scholar] [CrossRef][Green Version]
- Hu, J.; Afayibo, D.; Zhang, B.; Zhu, H.; Yao, L.; Guo, W.; Wang, X.; Wang, Z.; Wang, D.; Peng, H.; et al. Characteristics, pathogenic mechanism, zoonotic potential, drug resistance, and prevention of avian pathogenic Escherichia coli (APEC). Front. Microbiol. 2022, 13, 1049391. [Google Scholar] [CrossRef]
- Iorgoni, V.; Iancu, I.; Popa, I.; Gligor, A.; Orghici, G.; Sicoe, B.; Dreghiciu, C.; Purec, D.; Nistor, P.; Florea, B.; et al. First Report of Respiratory Infection Caused by Multidrug-Resistant Escherichia coli in an Ostrich in Romania. Antibiotics 2025, 14, 354. [Google Scholar] [CrossRef] [PubMed]
- Yun, J.; Mao, L.; Li, J.; Hao, F.; Yang, L.; Zhang, W.; Sun, M.; Liu, M.; Wang, S.; Li, W. Molecular characterization and antimicrobial resistance profile of pathogenic Escherichia coli from goats with respiratory disease in eastern China. Microb. Pathog. 2022, 166, 105501. [Google Scholar] [CrossRef]
- Jonker, A.; Gouws, J.; Kapp, E.; Henning, A. Isolation of a multidrug-resistant Escherichia coli pathotype Stx2:Cnf1:Cnf2:Eae as a potential cause of hemorrhagic diarrhea and secondary septicemia in a dog. J. Vet. Diagn. Investig. 2022, 34, 339–342. [Google Scholar] [CrossRef]
- Chongrattanameteekul, P.; Rattanaworapanit, N.; Wongsawan, K.; Chuammitri, P.; Anuntakulnatee, T.; Veerathong, S.; Mektrirat, R. Antimicrobial resistance and etiological dynamics affected by tropical climate variability on year-round diagnosis of upper respiratory infections in companion rabbits with snuffles. Sci. Rep. 2025, 15, 97690. [Google Scholar] [CrossRef] [PubMed]
- Rosell, J.; De La Fuente, L.; Badiola, J.; De Rozas, A.; De Luco, D.; Arnal, M.; Casal, J.; Fernández, X.; De Carvalho, A. Respiratory disorders of farmed rabbits: Occurrence and risk factors. World Rabbit Sci. 2023, 31, 147–161. [Google Scholar] [CrossRef]
- Divaret-Chauveau, A.; Foucaud, L.; Demoulin, B.; Teston, C.; Loison, P.; Cann, L.; Schweitzer, C.; De Carvalho Bittencourt, M.; Mauny, F.; Demoulin-Alexikova, S. Early exposure to farm dust in an allergic airway inflammation rabbit model: Does it affect bronchial and cough hyperresponsiveness? PLoS ONE 2023, 18, e0279498. [Google Scholar] [CrossRef]
- Oyewo, M.; Al-Mustapha, A.; Richards, B.; Olasoju, T.; Babale, S.; Khalid, H.; Meseko, C.; Balogun, M. Preliminary Outbreak Investigation and Spatial Epidemiology of Rabbit Hemorrhagic Disease Outbreak in Nigeria. Front. Vet. Sci. 2022, 8, 771599. [Google Scholar] [CrossRef]
- Huneau-Salaün, A.; Boucher, S.; Fontaine, J.; Normand, B.; Lopez, S.; Maurice, T.; Nouvel, L.; Bruchec, A.; Coton, J.; Martin, G.; et al. Retrospective studies on rabbit haemorrhagic disease outbreaks caused by RHDV GI.2 virus on farms in France from 2013 to 2018. World Rabbit Sci. 2021, 29, 87–98. [Google Scholar] [CrossRef]
- Shapiro, H.; Ruder, M.; Nimlos, N.; Pienaar, E. Understanding rabbit owners’ willingness to engage in disease prevention behaviors. Prev. Vet. Med. 2023, 219, 106018. [Google Scholar] [CrossRef] [PubMed]
- Li, X.; Chen, M.; Chen, T.; Xie, L.; Luo, Q.; Fan, X.; Yin, Y.; Meng, S.; Jin, Z.; He, Y.; et al. The Intricate Interplay among Microbiota, Mucosal Immunity, and Viral Infection in the Respiratory Tract. J. Transl. Med. 2025, 23, 488. [Google Scholar] [CrossRef] [PubMed]
- Xin, C.; Hill, F.; Elsohaby, I. Retrospective Analysis of Antimicrobial Resistance in Bacterial Pathogens from Pet Rabbits in Hong Kong, 2019–2022. J. Vet. Diagn. Investig. 2024, 36, 711–718. [Google Scholar] [CrossRef]
- Iorgoni, V.; Iancu, I.; Popa, I.; Gligor, A.; Orghici, G.; Sicoe, B.; Badea, C.; Dreghiciu, C.; Pop, C.; Bochiș, T.; et al. First Case of Respiratory Infection in Rabbits Caused by Alcaligenes faecalis in Romania. Vet. Sci. 2025, 12, 33. [Google Scholar] [CrossRef]
- Man, W.; De Steenhuijsen Piters, W.; Bogaert, D. The Microbiota of the Respiratory Tract: Gatekeeper to Respiratory Health. Nat. Rev. Microbiol. 2017, 15, 259–270. [Google Scholar] [CrossRef]
- Koenen, M.; De Steenhuijsen Piters, W.; Bogaert, D.; Verhagen, L. The Microbiota in Respiratory Tract Infections: From Association to Intervention. Curr. Opin. Infect. Dis. 2022, 35, 215–222. [Google Scholar] [CrossRef]
- Drigot, Z.; Clark, S. Insights into the Role of the Respiratory Tract Microbiome in Defense against Bacterial Pneumonia. Curr. Opin. Microbiol. 2024, 77, 102428. [Google Scholar] [CrossRef]
- Eid, H.; Gawad, N.; Zaghlol, E. Bacteriological Studies on Escherichia coli Infection in Rabbits. SCVMJ 2017, 22, 133–144. [Google Scholar] [CrossRef]
- Solans, L.; Arnal, J.; Sanz, C.; Benito, A.; Chacón, G.; Alzuguren, O.; Fernández, A. Rabbit Enteropathies on Commercial Farms in the Iberian Peninsula: Etiological Agents Identified in 2018–2019. Animals 2019, 9, 1142. [Google Scholar] [CrossRef] [PubMed]
- Zhao, X.; Yang, J.; Ju, Z.; Chang, W.; Sun, S. Molecular Characterization of Antimicrobial Resistance in Escherichia coli from Rabbit Farms in Tai’an, China. Biomed. Res. Int. 2018, 2018, 8607647. [Google Scholar] [CrossRef] [PubMed]
- Zhao, J.; Liu, Y.; Xiao, C.; He, S.; Yao, H.; Bao, G. Efficacy of Phage Therapy in Controlling Rabbit Colibacillosis and Changes in Cecal Microbiota. Front. Microbiol. 2017, 8, 957. [Google Scholar] [CrossRef]
- Simonová, M.; Lauková, A.; Chrastinová, L.; Strompfová, V.; Faix, Š.; Vasilková, Z.; Ondruška, Ľ.; Jurčík, R.; Rafay, J. Enterococcus faecium CCM7420, Bacteriocin PPB CCM7420 and Their Effect in the Digestive Tract of Rabbits. Czech J. Anim. Sci. 2018, 54, 376–386. [Google Scholar] [CrossRef]
- Aboelhadid, S.; Hashem, S.; Abdel-Kafy, E.; Mahrous, L.; Farghly, E.; Abdel-Baki, A.; Al-Quraishy, S.; Kamel, A. Prebiotic Supplementation Effect on Escherichia coli and Salmonella Species Associated with Experimentally Induced Intestinal Coccidiosis in Rabbits. PeerJ 2021, 9, e10714. [Google Scholar] [CrossRef]
- Ertas Onmaz, N.; Demirezen Yilmaz, D.; Imre, K.; Morar, A.; Gungor, C.; Yilmaz, S.; Gundog, D.A.; Dishan, A.; Herman, V.; Gungor, G. Green Synthesis of Gold Nanoflowers Using Rosmarinus officinalis and Helichrysum italicum Extracts: Comparative Studies of Their Antimicrobial and Antibiofilm Activities. Antibiotics 2022, 11, 1466. [Google Scholar] [CrossRef] [PubMed]
- Kupczyński, R.; Szumny, A.; Bednarski, M.; Piasecki, T.; Śpitalniak-Bajerska, K.; Roman, A. Application of Pontentilla anserine, Polygonum aviculare and Rumex crispus Mixture Extracts in a Rabbit Model with Experimentally Induced E. coli Infection. Animals 2019, 9, 774. [Google Scholar] [CrossRef]
- Ismail, A.; Abdien, H.; Hamed, D.; Feil, W. Prevalence of Some Enteric Bacterial Infections Causing Rabbit Enteritis and Attempts to Control Rabbit Coli Enteritis with Phytobiotics. Zagazig Vet. J. 2017, 45, 91–101. [Google Scholar] [CrossRef]
- Massella, E.; Giacometti, F.; Bonilauri, P.; Reid, C.J.; Djordjevic, S.P.; Merialdi, G.; Bacci, C.; Fiorentini, L.; Massi, P.; Bardasi, L.; et al. Antimicrobial Resistance Profile and ExPEC Virulence Potential in Commensal Escherichia coli of Multiple Sources. Antibiotics 2021, 10, 351. [Google Scholar] [CrossRef]
- Iancu, I.; Al Kaddah, Y.; Cătana, N.; Degi, J.; Pascu, C.; Herman, V. Evaluation of Antimicrobial Resistance in Strains of Escherichia coli Isolated from Broiler Carcasses. Rev. Rom. Med. Vet. 2018, 28, 35–38. [Google Scholar]
- Stanga, L.C.; Vaduva, D.M.B.; Grigoras, M.L.; Nussbaum, L.A.; Gurgus, D.; Strat, L.; Zamfir, A.S.; Poroch, V.; Folescu, R. Nosocomial Infections Distribution and Impact in Medical Units. Rev. Chim. 2019, 70, 2265–2268. [Google Scholar] [CrossRef]

Disclaimer/Publisher’s Note: The statements, opinions and data contained in all publications are solely those of the individual author(s) and contributor(s) and not of MDPI and/or the editor(s). MDPI and/or the editor(s) disclaim responsibility for any injury to people or property resulting from any ideas, methods, instructions or products referred to in the content. |
© 2025 by the authors. Licensee MDPI, Basel, Switzerland. This article is an open access article distributed under the terms and conditions of the Creative Commons Attribution (CC BY) license (https://creativecommons.org/licenses/by/4.0/).
Share and Cite
Iorgoni, V.; Stanga, L.; Iancu, I.; Degi, J.; Popa, I.; Gligor, A.; Orghici, G.; Sicoe, B.; Dreghiciu, I.C.; Purec, D.; et al. Multidrug-Resistant Escherichia coli Associated with Respiratory and Systemic Infection in a Domestic Rabbit in Romania: First Confirmed Case. Antibiotics 2025, 14, 929. https://doi.org/10.3390/antibiotics14090929
Iorgoni V, Stanga L, Iancu I, Degi J, Popa I, Gligor A, Orghici G, Sicoe B, Dreghiciu IC, Purec D, et al. Multidrug-Resistant Escherichia coli Associated with Respiratory and Systemic Infection in a Domestic Rabbit in Romania: First Confirmed Case. Antibiotics. 2025; 14(9):929. https://doi.org/10.3390/antibiotics14090929
Chicago/Turabian StyleIorgoni, Vlad, Livia Stanga, Ionica Iancu, Janos Degi, Ionela Popa, Alexandru Gligor, Gabriel Orghici, Bogdan Sicoe, Ioan Cristian Dreghiciu, David Purec, and et al. 2025. "Multidrug-Resistant Escherichia coli Associated with Respiratory and Systemic Infection in a Domestic Rabbit in Romania: First Confirmed Case" Antibiotics 14, no. 9: 929. https://doi.org/10.3390/antibiotics14090929
APA StyleIorgoni, V., Stanga, L., Iancu, I., Degi, J., Popa, I., Gligor, A., Orghici, G., Sicoe, B., Dreghiciu, I. C., Purec, D., Nistor, P., Florea, B., Kracunović, C., & Herman, V. (2025). Multidrug-Resistant Escherichia coli Associated with Respiratory and Systemic Infection in a Domestic Rabbit in Romania: First Confirmed Case. Antibiotics, 14(9), 929. https://doi.org/10.3390/antibiotics14090929

